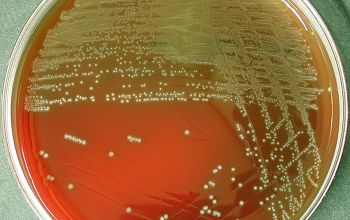

Lactobacillus salivarius (Ligilactobacillus salivarius)
-
General information
Lactobacillus species produce lactic acid as their single or major metabolic end product from glucose fermentation
Taxonomy
Family: Lactobacillaceae
Genus: Ligilactobacillus salivarius
Formely: Lactobacillus salivarius
Natural habitats
They are widely distributed in the environment
They belong to the normal flora of the intestine, urogenital tract and mouth.
Clinical significance
Despite the reputation of lactobacilli as beneficial organisms, they can be involved in serious infections, especially in immunocompromised individuals.
Lactobacilli are particularly associated with advanced dental caries, where they are considered a secondary colonizer because of their preference for low-pH habitats, but probaply play a role in exacerbating existing lesions.
The clinical infections most commonly caused by lactobacilli are bacteremia and endocarditis, with an associated relatively high mortality rate, with the mouth, the primary route of entry to the bloodstream.
-
Gram stain
Gram positive rods, short or long, slender: in chains
with rounded ends, occurring singly, in pairs, and in chains.
0.6-0.9 x 1.5-5.0 µm,
-
Culture characteristics
-
Facultative anaerobic
5% CO2 stimulates growth
Lactobacillus: are small, convex, opaque colonies without pigment with sometimes a greening zone (morphology of a greening streptococcus) or aging of the medium
L. salivarius
BA: colonies are convex, opaque and a greening zone (morphology of a greening streptococcus) or aging of the medium
McConkey: no growth (variable)
BBAØ: growth (they grow better anaerobic)
-
-
Characteristics
-
References
James Versalovic et al.(2011) Manual of Clinical Microbiology 10th Edition
Karen C. Carrol et al (2019) Manual of Clinical Microbiology, 12th Edition